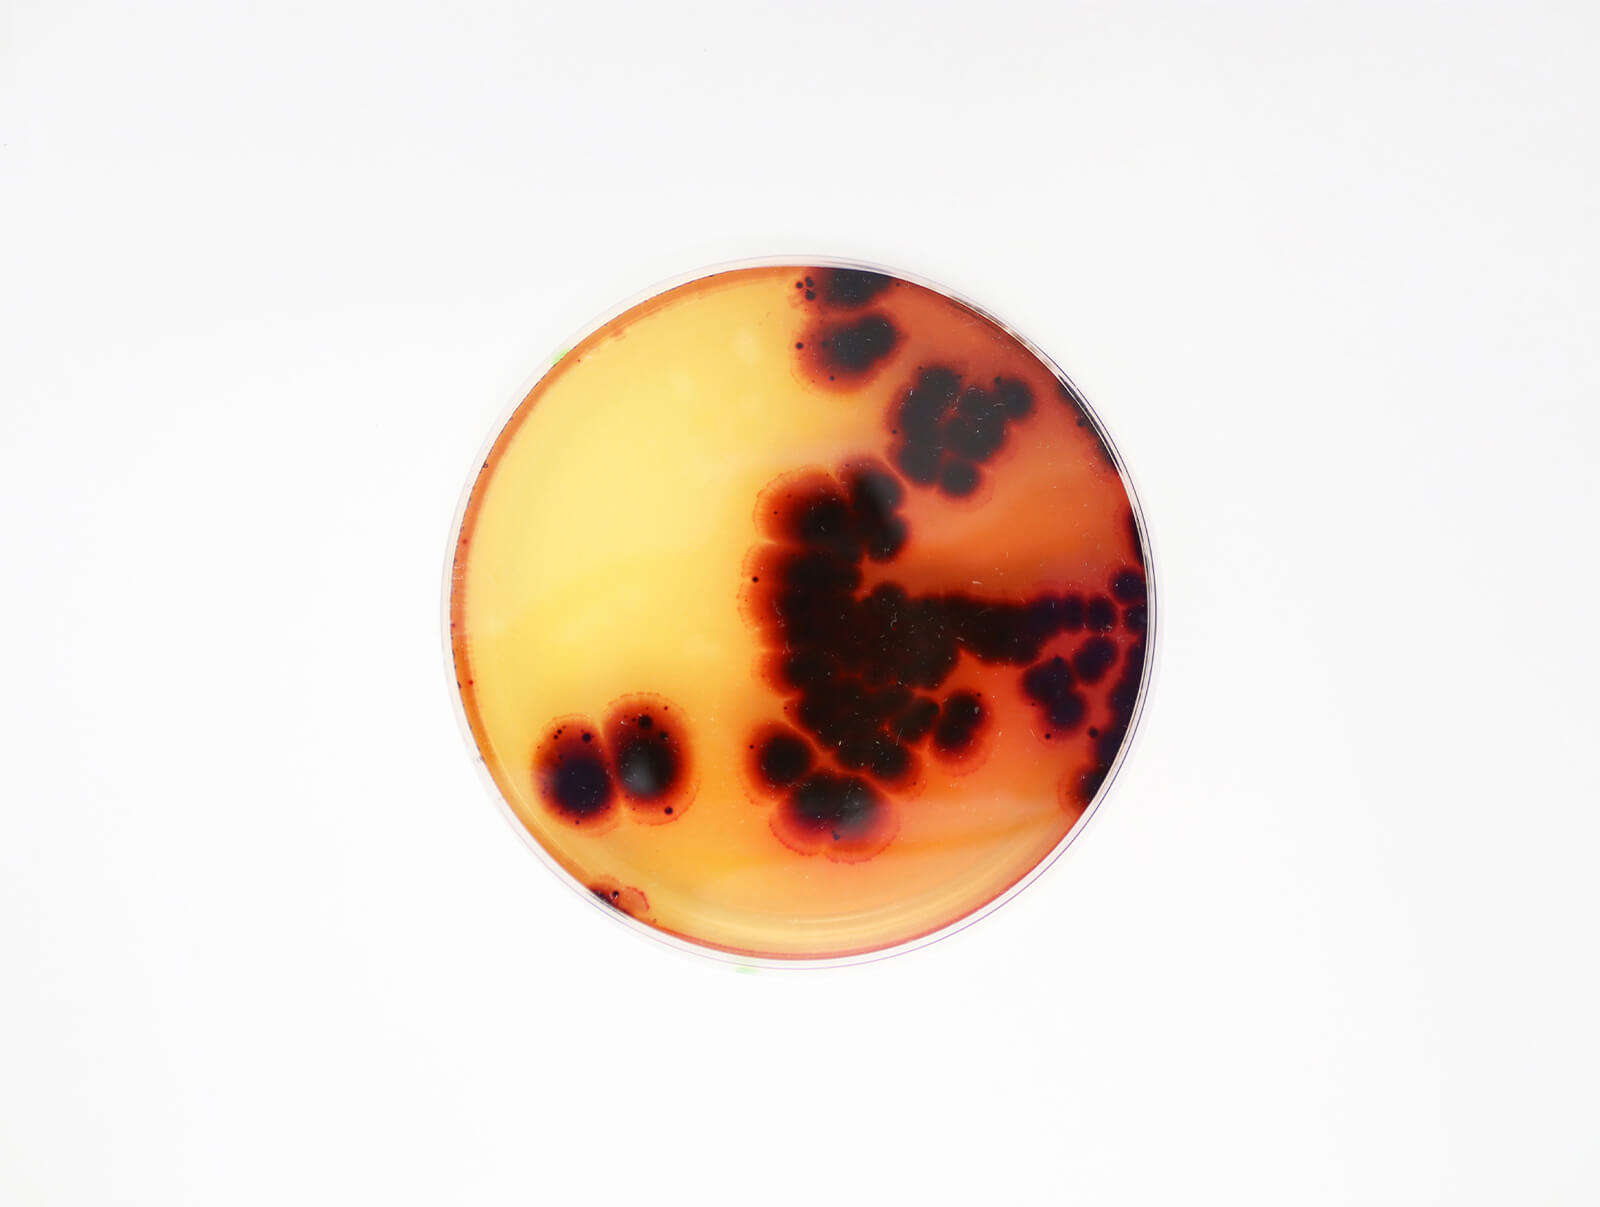

Goldwin Play Earth Fund PORTFOLIO INTRODUCTION
Vol.4Dimpora
スイス発のスタートアップ「Dimpora」。
ーまずは、簡単な自己紹介からお願いします。
マリオ:「Dimpora」のCEO兼共同設立者のマリオ・シュトゥッキです。スイスのチューリッヒ工科大学で化学工学と生物工学を学び、PhD(日本の「博士号」にあたるもの)も取っています。
ー大学時代に、持続可能なメンブレンの研究をはじめたとうかがいました。
マリオ:はい。大学在学中、修士プロジェクトと博士研究の一環として、従来のメンブレンに代わる持続可能な素材の研究に取り組み始めました。
ーその研究が、いまのビジネスにつながったと。
マリオ:そうですね。具体的に言えば、当時はレインウェア用のフッ素フリー素材を開発していたんです。従来のパフォーマンスウェアの機能はそのままに、持続可能な素材を作れないかと。もし実現できたなら、アウトドアウェアが与える環境へのインパクトを減らせると思いましたし、同時に大きな変革を起こせると思ったんです。博士課程でさらに改良を重ね、この技術をもっと広めたいと思い、2019年に同僚のアンナと一緒に「Dimpora」を設立しました。
ー「Dimpora」が掲げるミッションも聞かせてください。
マリオ:私たちは、高性能と持続可能性が両立できることを証明するために、素材開発を進めています。そして、目標はいたってシンプル。アウトドアブランドが、人と地球を守るギアを作る手助けをすることです。
ーマリオさん自身、アウトドアアクティビティがお好きだったんでしょうか?
マリオ:もちろん! ぼくはスイスで育ったので、自然の中で過ごすことが日常でしたからね。ハイキングやスキー、フィッシングなんかをすることが多かったです。ただ、そうしたアクティビティは単なる趣味ではなく、私たちが守ろうとしている環境と繋がる方法でもありました。自然に身をおくことで、環境の変化をつぶさに感じられるし、なによりこの環境を守っていきたいと強く感じたんです。アウトドアとの個人的なつながりが「Dimpora」が誕生した理由の大きな部分であるし、ここまで熱量高く、ぼくが素材の開発に打ち込む理由です。
自然が好きなのに、自然を破壊してしまっている矛盾を解消する。
ー「Dimpora」といえば、フッ素化合物(PFAS)を使用していないメンブレンです。同プロダクトを開発しようと思った経緯を教えてください。
マリオ:持続可能性には興味があったのと、アウトドアが好きな人間として、自然の中で過ごすときのウェアに、どんなものが使われているのか疑問を持ち始めました。調べてみると、ウェアのほとんどが、自然界で分解されず、環境や私たちの体内に蓄積されるフッ素系化学物質(PFCやPFAS)で作られたメンブレンに依存していることに気づいたんです。そのときに、自然を愛しながら、それを害するものを身につけるという矛盾も感じました。
ー 開発過程で、印象に残っている出来事はありますか?
マリオ:初めて大規模生産を試みたときに、誰もが知る国際的なブランドから関心を持ってもらったんです。そのときはうれしかったですし、これは単なるアイデアではなく、業界が本当に必要としているものだとも確信しました。

ー表地や裏地でもなく、メンブレンとラミネートに目をつけた理由はあるのでしょうか?
マリオ:メンブレンは目に見えないものですが、アウトドアウェアにとっては最も大切。フィールドでの快適さと不快さを分ける鍵です。でも、残念ながらその多くが環境に配慮されていません。それはチャンスだと思ったと同時に、挑戦しがいがあると思ったんです。ニッチな分野ですが、あらゆる側面で好影響を与えられると。
ー「Dimpora」のメンブレンの特徴を教えてください。
マリオ:私たちのメンブレンはすべて、特許取得済みのコアレイヤー・テクノロジーというものを使っています。結果、有害な溶剤を使わず、従来のものに比べCO2排出量を92%削減できています。これは私たちの誇りであり、一緒に取り組むにブランドの持続可能性目標の達成にも貢献しています。

ー現在の主力製品にはどのようなものがありますか?
マリオ:Dimpora®、Dimpora®BIO、Dimpora®MONOの3つの製品があります。まず、Dimpora®はポリプロピレンから作った最も防水性が高い製品です。Dimpora®BIOは、60%以上がバイオベース(ヒマシ油由来)を使った微多孔膜。Dimpora®MONOは、当社のモノマテリアル(単一の素材で造られた製品)です。素材が混ざりあっていないため、衣服の寿命が尽きたとしてもリサイクルが非常にしやすくなっています。

ー現在開発中の新製品やイノベーションについても教えてください。
マリオ:ワクワクするプロジェクトが2つあります。ひとつ目は、Dimpora®BIO MONO。この種の製品としては初となる、バイオベースのモノマテリアル・メンブレンです。この開発が成功すれば、真の循環性を実現できると思っていますし、アウトドアウェアがブレイクスルーするきっかけになるとも思います。
ーもうひとつのプロジェクトは何でしょうか?
マリオ:もうひとつがDimpora®3D。テキスタイルに直接スプレーやコーティングできる、流動性のあるメンブレンです。これがあれば、縫い目や接着剤、複数のレイヤーが不要になって、廃棄物も減らせます。いまは、一緒に開発してくれるパートナーを探しているところなんです。
思いを同じくする企業と、新しい世界を切り拓く。
ー現在、「Dimpora」には多くの企業が投資していると思いますが、その投資家たちは、どんな面々なのでしょうか?
マリオ:とても協力的で、素晴らしい経験と視点を持っている方々です。また、私たちのネットワーク、リーチ、スキルを補完してくれるパートナーでもあります。また、これからはより戦略的な連携が重要で、お金以上のものをもたらしてくれる協力者が必要です。理想は、成長を加速させて影響力を広げる手助けをしてくれる人たち。Goldwin Play Earth Fundはまさにそうなんです。
ーGoldwin Play Earth Fundも「Dimpora」への出資を決めました。そこまでの経緯を教えてください。
マリオ:最初は、共通の知人から紹介されました。そこから互いを知るうちに、自然と話が発展して、最終的には投資の話になったんです。印象的だったのは、製品のビジョンや品質だけでなく、ビジネスの長期的な考え方や価値観がとても似ていたこと。何度も会って時間をかけて話し合い、急がずに相互理解を深めていきました。

ーゴールドウインのビジネスや哲学に共感する部分はありますか?
マリオ:もちろんです。自然と調和するというゴールドウインの哲学は、私たちの使命と同じ。機能的なデザインを重視し、素材革新に力を入れている点も素晴らしいと思います。持続可能な方法で限界を広げようとする姿勢も、私たちにとって刺激になっています。
ーこのパートナーシップがもたらす相乗効果についてはどうお考えですか?
マリオ:きっと、アウトドア業界における持続可能性の新基準となる製品を生み出せると思います。高性能と環境への責任が両立できることを示せれば、業界や消費者の期待値を上げることができますよね。
ー最後に、「Dimpora」の今後のビジョンについて教えてください。
マリオ:私たちのビジョンは、繊維産業における「性能」の意味を再定義することです。さらに、持続可能性が当たり前になる世界を目指しています。そして私たちは、あくまで素材メーカー。アウトドアブランドが環境に悪影響を与えず、高性能な製品を作れるよう、これからも支援していきたいです。いつか、世界で最も先進的なウェアが、最も持続可能なウェアになることが、私たちの夢なんです。
Text_Keisuke Kimura
Edit_Shuhei Wakiyama(HOUYHNHNM / Rhino inc.)